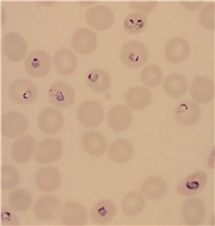

Denna information gör inte anspråk på att vara heltäckande eller ständigt uppdaterad utan syftar till att ge en överblick över smittsamma sjukdomar av betydelse för smittskyddsarbete.
Sjukdomsinformation om malaria
Malaria är en mycket utbredd sjukdom i tropiska och subtropiska delar av världen. Sjukdomen sprids via myggor. De allra flesta malariadödsfall drabbar barn under fem år i Afrika söder om Sahara.
Sidans information
Vad orsakar malaria och hur sprids sjukdomen?
Vad orsakar malaria och hur sprids sjukdomen?
Malaria orsakas av encelliga organismer, så kallade protozoer, som tillhör släktet Plasmodium. Det finns flera olika arter av Plasmodium och de som oftast orsakar sjukdom hos människa är P. falciparum, P. vivax, P. ovale och P. malariae. Även fler arter, däribland P. knowlesi kan orsaka sjukdom hos människa men är mer sällsynta. P. falciparum orsakar allvarligast sjukdom och är orsaken till praktiskt taget alla dödsfall i malaria.
Malaria sprids via Anophelesmyggan, som även finns i Sverige. Malaria (P. vivax) har funnits i Sverige men sjukdomen försvann på 1930-talet (se nedan). De fall som nu rapporteras i Sverige har uteslutande smittats utomlands i olika tropiska områden.
Förekomsten av malaria varierar inom tropikerna och smittrisken varierar kraftigt mellan olika områden. De flesta fallen bland resenärer från Sverige har smittats i Afrika och majoriteten av dessa är orsakade av P. falciparum. Bland de övriga fallen, som smittats i Asien eller Syd- och Mellanamerika, dominerar P. vivax.
I Europa är inte sjukdomen etablerad, men enstaka fall kan sporadiskt rapporteras i närheten av flygplatser då smittade myggor kan följa med flygtrafiken. Ett fåtal fall av malaria utan resehistorik förekommer sporadiskt i södra Europa.
Symtom och behandling
För P. falciparum är inkubationstiden i regel en till två veckor, men kan vara betydligt längre än så. För vissa av de andra arterna kan den uppgå till flera år eftersom vissa malariaparasiter kan ligga vilande i levern.
Karaktäristiska symtom vid malaria är periodvis återkommande feber och frossa varannan eller var tredje dag. Andra symtom kan vara illamående, huvudvärk och muskelvärk. Vid en infektion med P. falciparum är febern ofta kontinuerlig och patienten kan bli medvetslös, få svåra diarréer och utveckla chock. Därför är det viktigt med tidig diagnostik och behandling. Sjukdomsbilden vid infektion med övriga malariaarter är oftast betydligt mildare.
Det finns flera effektiva läkemedel mot malaria.
Epidemiologisk övervakning och mikrobiologisk diagnostik
Sjukdomens utbredning övervakas av Folkhälsomyndigheten genom smittskyddsanmälningar och omvärldsbevakning.
Diagnos kan ställas genom antigenpåvisning (snabbtest) av blod, fynd av malariaplasmodier i blod vid mikroskopi, eller genom att påvisa malariaparasitens arvsmassa med molekylärbiologiska metoder (PCR och LAMP). Endast snabbtest är inte tillräckligt för att bekräfta eller avfärda diagnosen.
Primärdiagnostik med mikroskopi och snabbtest utförs inte rutinmässigt vid Folkhälsomyndigheten, men myndigheten utför artbestämning av påvisad malaria.
Antikroppspåvisning i serum kan ha betydelse för verifiering av malariadiagnos i efterhand samt vid undersökning av blodgivare och vid misstanke om så kallat hyperreactive malarial splenomegaly syndrome. Antikroppspåvisning ska inte användas för akut malariadiagnostik.
Analyskatalog för mikrobiologiska analyser och tjänster
Förebyggande åtgärder
Det går att minska risken för myggöverförda smittor genom att skydda sig mot myggstick.
- Smörj in huden med myggmedel och sov under myggnät, helst impregnerat.
- Sov i rum med en fläkt eller luftkonditionering, eftersom det i viss mån håller myggen borta.
- Använd gärna täckande kläder, till exempel en långärmad tröja och långbyxor
Det är rekommenderat att ta förebyggande läkemedel (profylax) vid resa till vissa områden där malaria finns. Dock ger profylax inte ett hundraprocentigt skydd och därför är det viktigt att även skydda sig mot myggstick.
Malaria kan även spridas via blodtransfusion och kan därför påverka ens möjlighet att vara blodgivare.
Ännu finns inget resevaccin mot malaria. Det finns dock två olika vaccin som godkänts av WHO och ges till barn i områden med hög risk för malaria.
Anmälan och åtgärder vid inträffade fall eller utbrott
Malaria är en anmälningspliktig sjukdom enligt smittskyddslagen och inträffade fall anmäls till smittskyddsläkaren i regionen och Folkhälsomyndigheten.
Mer om anmälningspliktiga sjukdomar
Kommentar
Malaria försvann från Sverige på 1930-talet bland annat tack vare insatser inom jordbruket i form av utdikning av våtmarker och torrläggning av myrar, vilket minskade kläckningsmöjligheterna för malariamyggan. Troligen bidrog även bättre bostäder på landsbygden samt en förbättrad djurhållning till att malaria försvann. Därtill kom bättre tillgänglighet till läkemedel, vilket minskade antalet smittade och därigenom också riskerna för smittspridning.
